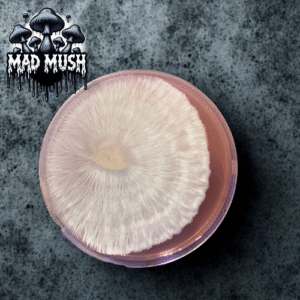
Lazy Tim Research Plate

cultures
Showing 1–32 of 1611 resultsSorted by latest
-
See more products by: Mr. Mycelium
Customer’s Choice 5 Pack Syringe Bundle
Original price was: $60.00.$50.00Current price is: $50.00. -
See more products by: Controlled Chaos Genetics
Steel Magnolia Research Plate 60mm
Original price was: $15.00.$12.00Current price is: $12.00. -
See more products by: Controlled Chaos Genetics
Pearly Gates Research Plate 60mm
Original price was: $15.00.$12.00Current price is: $12.00. -
See more products by: Controlled Chaos Genetics
Trinity X Ape Research Plate 60mm
Original price was: $15.00.$12.00Current price is: $12.00. -
See more products by: Controlled Chaos Genetics
Blueberry Ape Research Plate 60mm
Original price was: $15.00.$12.00Current price is: $12.00. -
See more products by: Happi Hyphae
-
See more products by: Marvelous Mikes Fungal Forge
-
See more products by: Mad Mush
Puff Puff Research Plate
$15.00 -
See more products by: BioTron Genetics
Yeti Research Syringe – 10ml
$15.00 -
See more products by: Marvelous Mikes Fungal Forge
Blue Magnolia Research Plate
$15.00 -
See more products by: Marvelous Mikes Fungal Forge
-
See more products by: Marvelous Mikes Fungal Forge
Burma Research Plate
$15.00 -
See more products by: Marvelous Mikes Fungal Forge
Cambodian Research Plate
$15.00 -
See more products by: Marvelous Mikes Fungal Forge
Fiji Research Plate
$15.00 -
See more products by: Marvelous Mikes Fungal Forge
Taman Negara Research Plate
$15.00 -
See more products by: Marvelous Mikes Fungal Forge
Lizard King Research Plate
$15.00 -
See more products by: Marvelous Mikes Fungal Forge
Escondido Research Plate
$15.00 -
See more products by: Marvelous Mikes Fungal Forge
Ecuador Research Plate
$15.00 -
See more products by: Marvelous Mikes Fungal Forge
4 Pack Fungal Forged Research Plates
Original price was: $45.00.$40.00Current price is: $40.00. -
See more products by: Marvelous Mikes Fungal Forge
Nepal Chitwan Research Plate
$15.00 -
See more products by: Marvelous Mikes Fungal Forge
Shakti Research Plate
$15.00 -
See more products by: Marvelous Mikes Fungal Forge
-
See more products by: Marvelous Mikes Fungal Forge
-
See more products by: Wombat Labs
-
See more products by: Mr. Mycelium
10 Research Syringe Genetics Of Your Choice
Original price was: $100.00.$90.00Current price is: $90.00. -
See more products by: The Fungus Frequency
Inky Anemone Research Plate
Original price was: $25.00.$20.00Current price is: $20.00. -
See more products by: Mr. Mycelium
-
See more products by: Marvelous Mikes Fungal Forge
Tidal Wave Research Plate
$15.00 -
See more products by: The Fungus Frequency
Albino A+ Research Plate
Original price was: $25.00.$20.00Current price is: $20.00. -
See more products by: The Fungus Frequency
MoonBit Research Plate
Original price was: $25.00.$20.00Current price is: $20.00. -
See more products by: The Fungus Frequency
Fairy Dust Research Plate
Original price was: $25.00.$20.00Current price is: $20.00. -
See more products by: The Fungus Frequency
TWAMAK Research Plate
Original price was: $25.00.$20.00Current price is: $20.00.